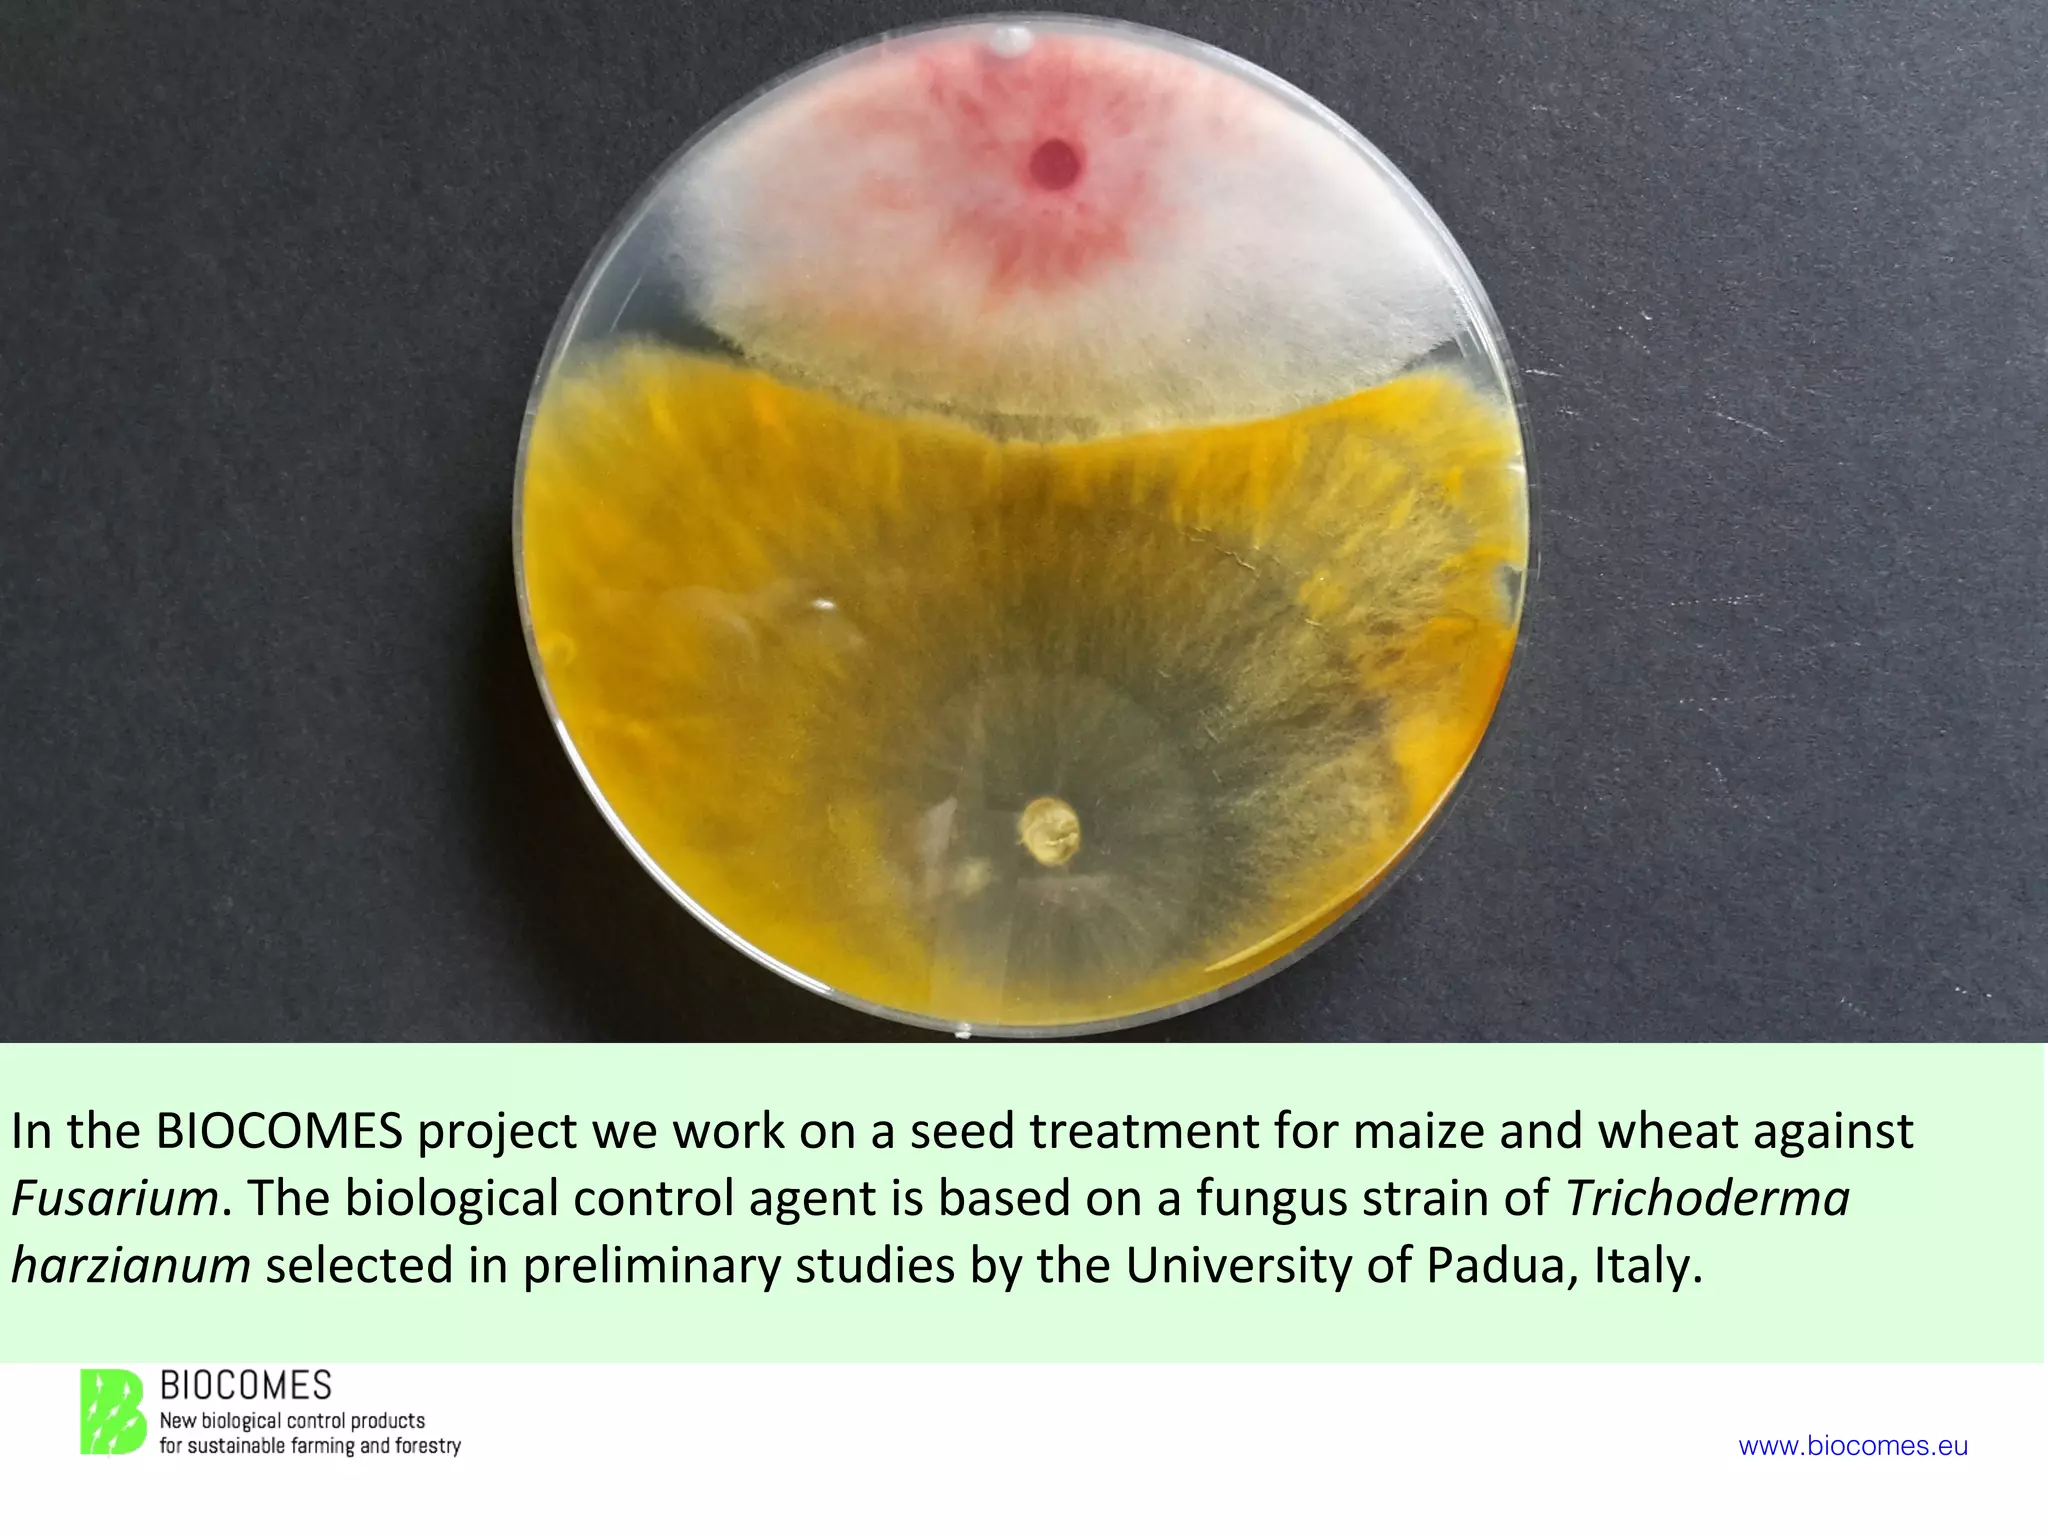
www.biocomes.eu
In the BIOCOMES project we work on a seed treatment for maize and wheat against
Fusarium. The biological control agent is based on a fungus strain of Trichoderma
harzianum selected in preliminary studies by the University of Padua, Italy.
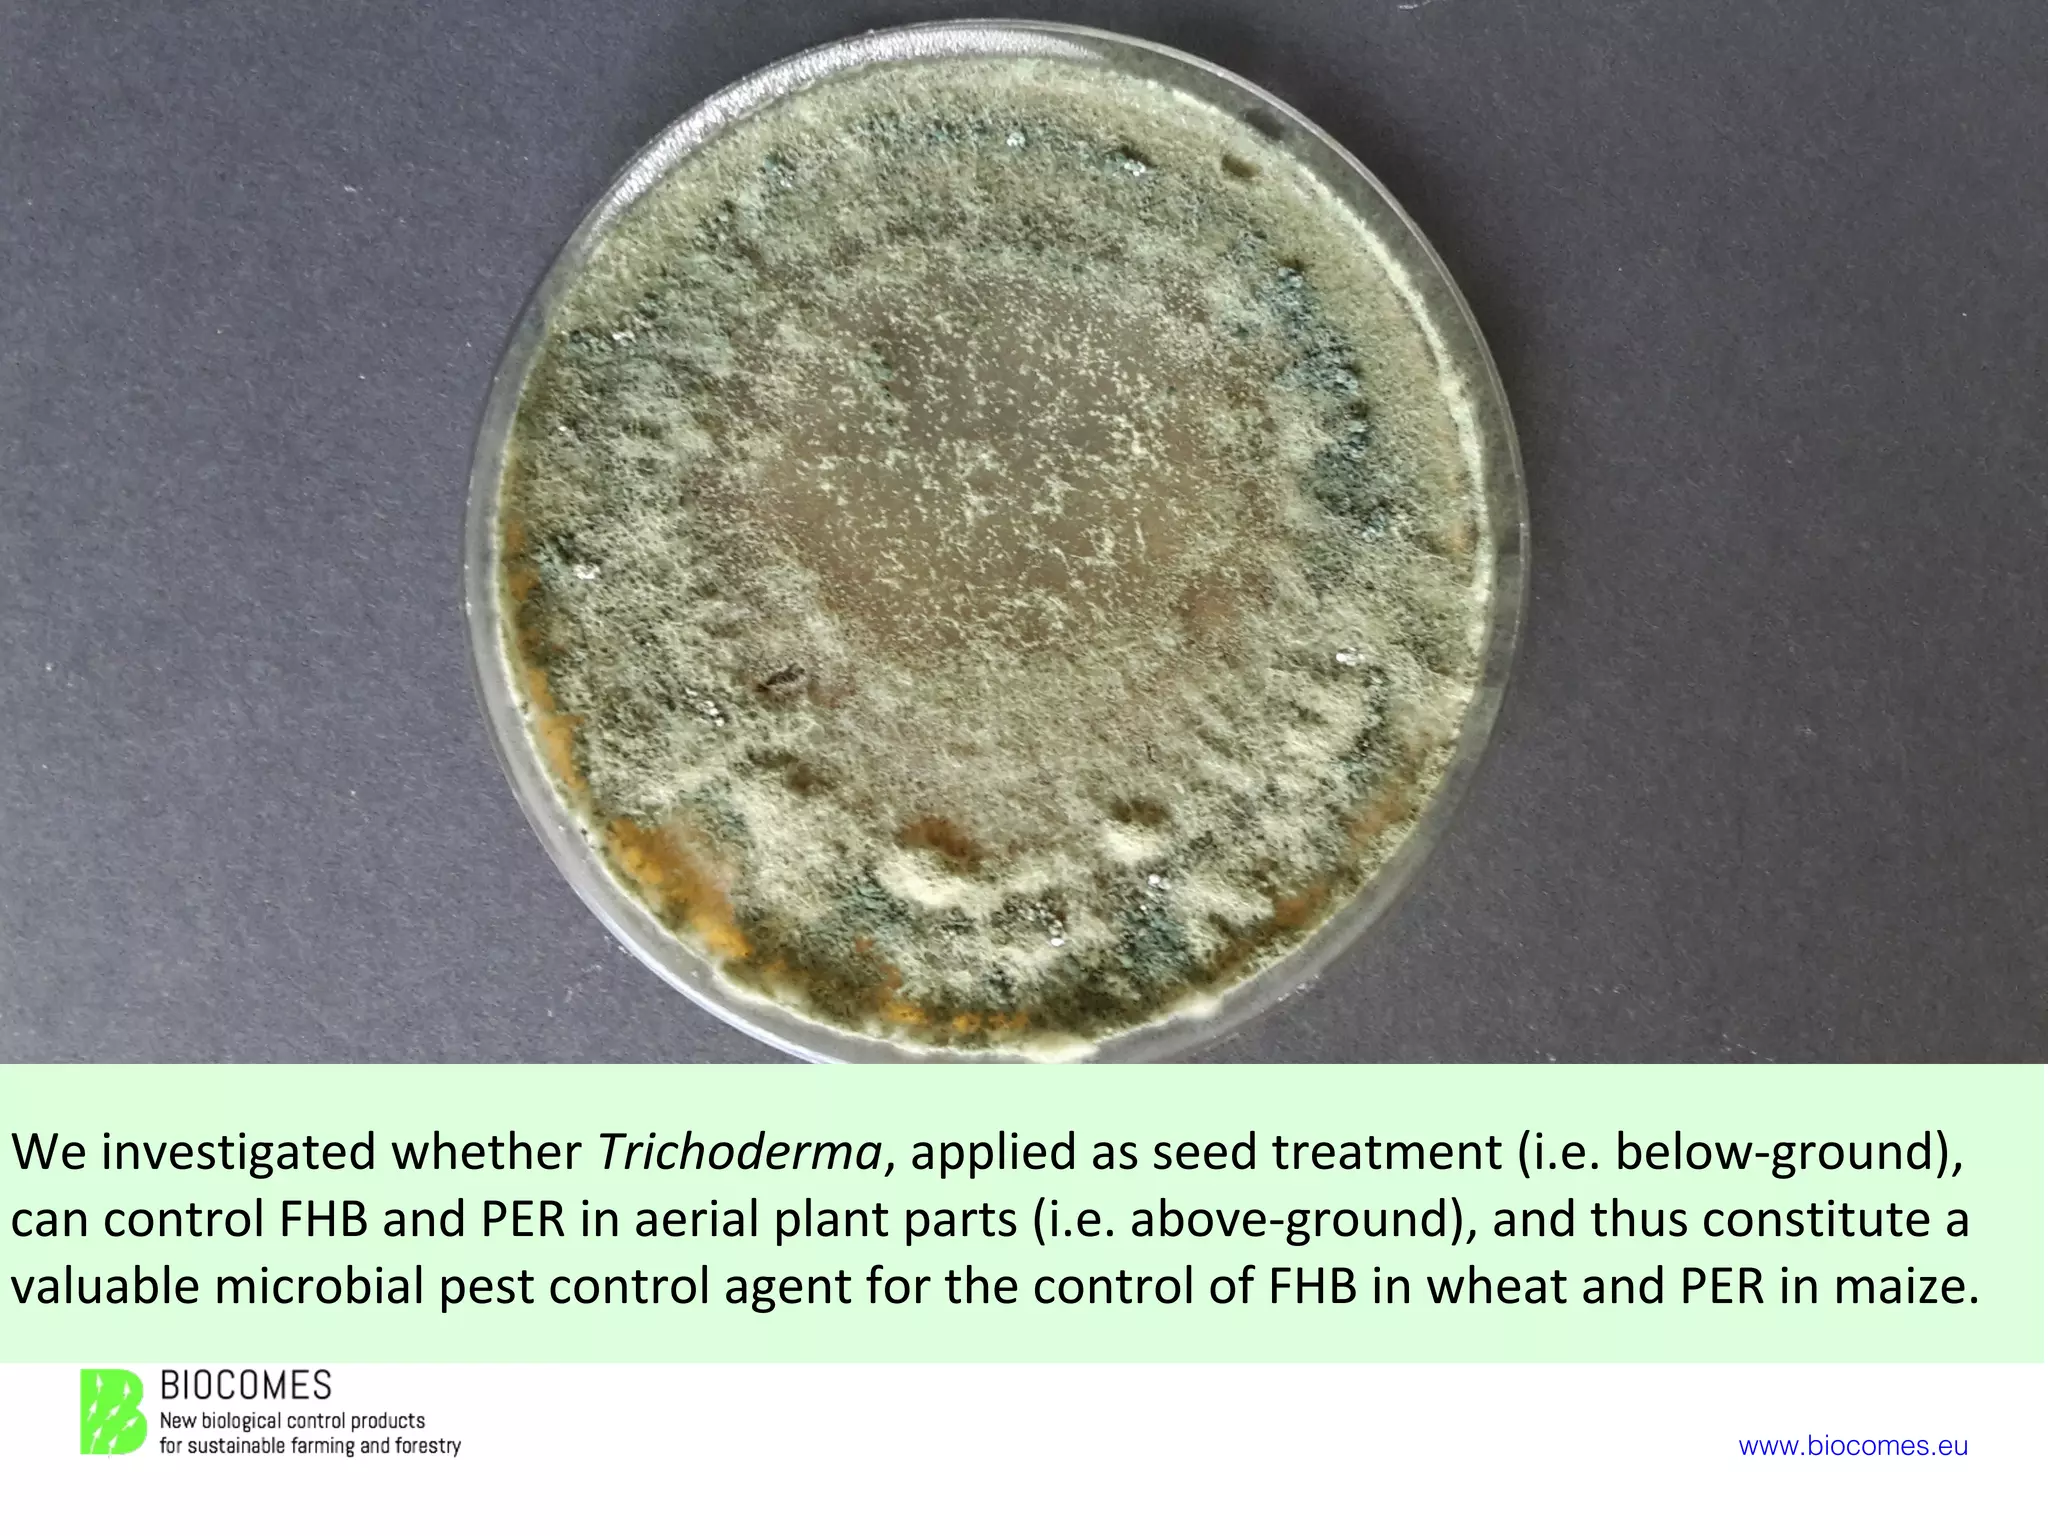
www.biocomes.eu
We investigated whether Trichoderma, applied as seed treatment (i.e. below-ground),
can control FHB and PER in aerial plant parts (i.e. above-ground), and thus constitute a
valuable microbial pest control agent for the control of FHB in wheat and PER in maize.
Foto: G. Barloggio
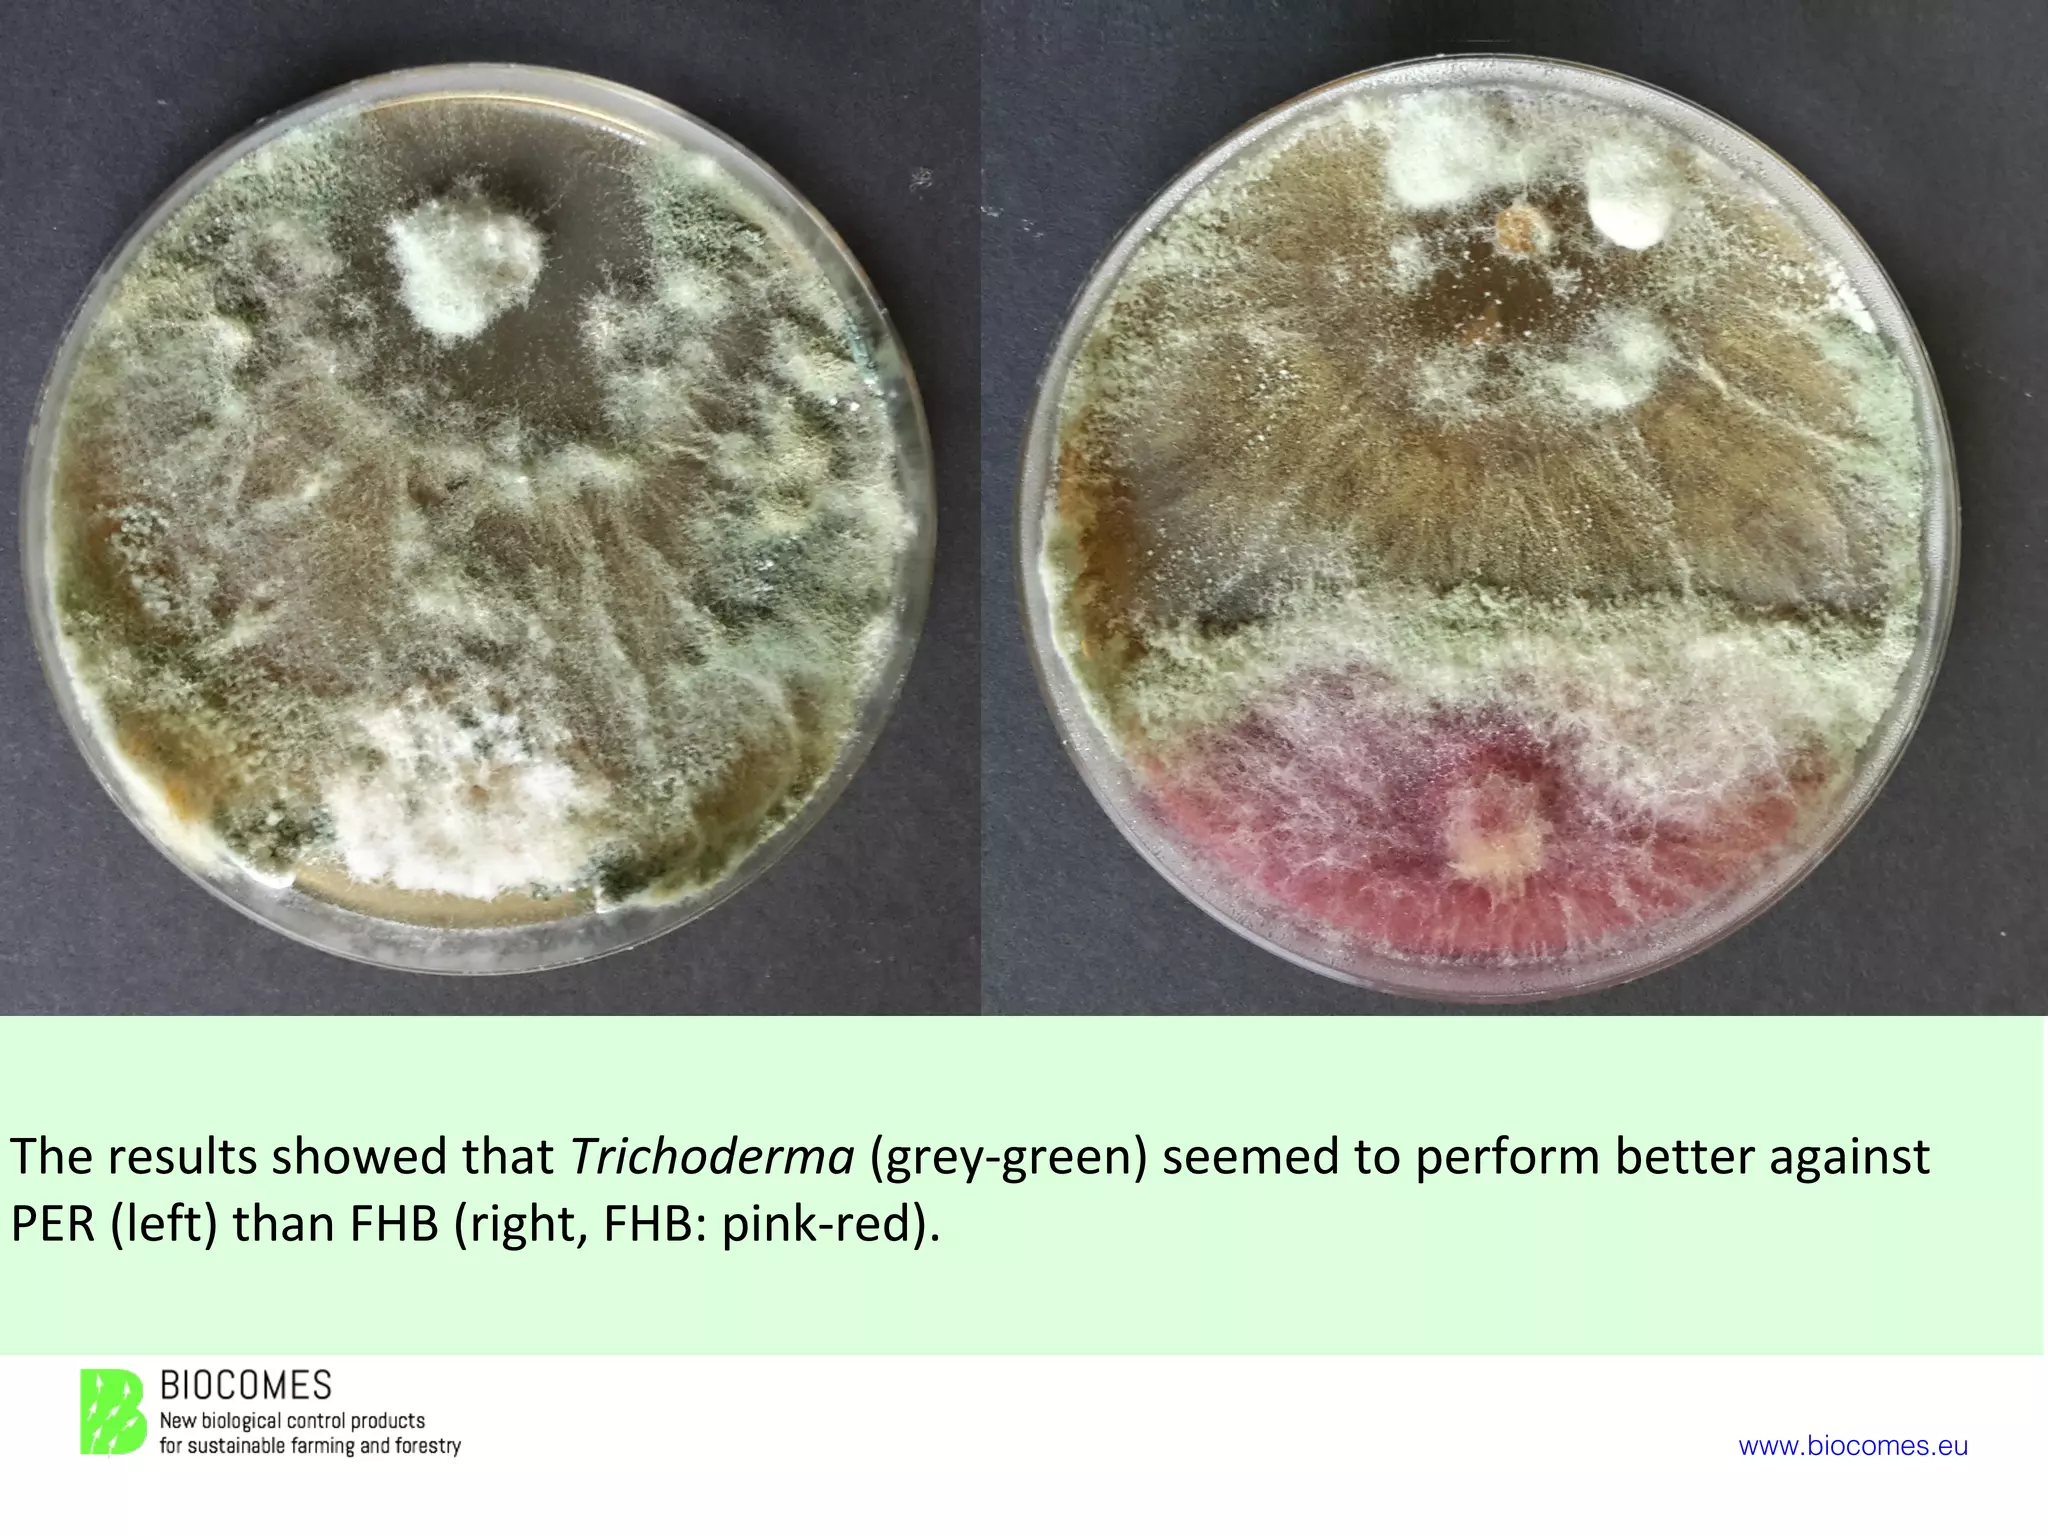
www.biocomes.eu
The results showed that Trichoderma (grey-green) seemed to perform better against
PER (left) than FHB (right, FHB: pink-red).

The BIOCOMES project involves 27 partners developing 11 biological control products, including a seed treatment using the fungus Trichoderma harzianum to control Fusarium head blight in wheat and pink ear rot in maize. Laboratory and greenhouse studies showed Trichoderma has the potential to control these above-ground diseases when applied below-ground as a seed treatment. Field trials were conducted in multiple countries in 2016 and 2017 to validate Trichoderma's ability to reduce Fusarium disease symptoms and mycotoxin levels in wheat and maize crops under natural conditions.